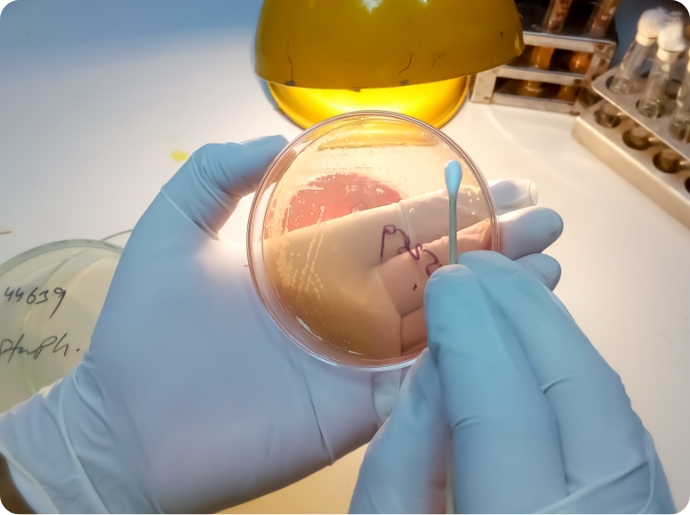
Scientist holding a vial

Clinical Trial
Advanced Cancer Care Through Clinical Trials
Columbia Asia Hospital – Bukit Rimau has been pioneering clinical trials in cancer care, providing patients access to innovative treatments under expert guidance. Partnering with Clinical Research Malaysia, our dedicated team ensures high-quality, safe, and effective trials that advance oncology research. Participating patients not only benefit from cutting-edge therapies but also contribute to crucial progress in cancer treatment for future patients.
Clinical Trial Phases
Phase I
Objective: Assess safety, dosage, and side effects.
Participants: 20-100 healthy volunteers or those with the disease/condition.
Focus: Determine the best dose, how the treatment is metabolized, and how it is excreted.
Phase II
Objective: Evaluate effectiveness and further assess safety.
Participants: Several hundred people with the condition.
Focus: Determine if the treatment works and to collect more safety data.
Phase III
Objective: Confirm effectiveness, monitor side effects, and compare them to common treatments.
Participants: Hundreds to thousands of people.
Focus: Provide a comprehensive assessment of the treatment’s effectiveness and safety. Often the last phase before regulatory approval.
Phase IV
Objective: Gather more information after the treatment is approved and marketed.
Participants: Thousands of people in real-world settings.
Focus: Monitor long-term effectiveness and rare side effects, often comparing the new treatment with standard ones.
Why Oncology
Clinical Trials Are Crucial

Columbia Asia fosters knowledge exchange and innovation through healthcare conferences, bringing together industry experts, corporations and healthcare partners to collaboratively explore advancements in medical practices and administration.
Columbia Asia fosters knowledge exchange and innovation through healthcare conferences, bringing together industry experts, corporations and healthcare partners to collaboratively explore advancements in medical practices and administration.


Promoting holistic well-being, Columbia Asia encourages a healthy lifestyle among its healthcare partners through sports events, fostering camaraderie and physical fitness within the community.
Promoting holistic well-being, Columbia Asia encourages a healthy lifestyle among its healthcare partners through sports events, fostering camaraderie and physical fitness within the community.


At Columbia Asia, we prioritize teamwork and synergy by organizing get-together activities that enhance collaboration and communication, ensuring a cohesive and motivated healthcare community dedicated to providing exceptional patient care.
At Columbia Asia, we prioritize teamwork and synergy by organizing get-together activities that enhance collaboration and communication, ensuring a cohesive and motivated healthcare community dedicated to providing exceptional patient care.


The Clinical Trial Team
Kalaivani Thiagarajah
Operations Manager
Mohd Khairul Mohd Zamri
Radiotherapy/Clinical Trial Manager
Nishandra Poo Balan
Clinical Trial Coordinator
Swmia Jayalaksmi A/P Jeraman @ Jayaraman
Chemotherapy Nurse Manager
List of Clinical Trial
Study | Therapeutic | Diagnosis | Principal Investigator | Sponsor | Status |
|---|---|---|---|---|---|
A Phase II/III Randomized, Controlled Clinical Study of Allostim® vs. Best Standard of Care in Asian Subjects With Advanced Hepatocellular Carcinoma | Oncology (Interventional) | Advanced Hepatocellular Carcinoma | Dr. Kananathan A/L Ratnavelu | Mirror-Biologics, Inc | Active, Recruiting |
A Phase 1b/2, Open-Label, Randomized Study of Vudalimab in Combination With Chemotherapy or Pembrolizumab in Combination With Chemotherapy As First-Line Treatment in Patients With Advanced Non-Small Cell Lung Cancer | Oncology (Interventional) | Advanced Non-small
Cell Lung Cancer | Dr. Jayendran Dharmaratnam | Xencor | On Hold |
A Multicenter, Randomized, Double-Blind Trial To Demonstrate Similar Efficacy, Safety, and Immunogenicity of FYB206 (Keytruda Biosimilar Candidate) in Comparison to Keytruda (Pembrolizumab) as an Add-On to Chemotherapy in Treatment-Naïve Patients With Metastatic Non-Squamous Non-Small Cell Lung Cancer (LOTUS) | Oncology (Interventional) | Metastatic Non-Squamous Non-Small Cell Lung Cancer | Dr. Kananathan A/L Ratnavelu | Formycon AG | On Hold |
A Phase 3 Open-Label, Randomized, Active-Controlled, Multicenter Trial to Evaluate the Efficacy and Safety of BAY 2927088 in Comparison with SOC as a First-Line Therapy in Patients with Unresectable, Locally Advanced, or Metastatic NSCLC with HER2 Activating Mutations | Oncology (Interventional) | Locally Advanced or Metastatic Non-Small Cell Lung Cancer | Dr. Ahmad Sufian Bin Ab Rahman | Bayer AG | Active, Recruiting |
Find Answers to
Your Questions
Have a question in mind?
Here’s a list of what others often ask.
Early access to new therapies, close monitoring, and contributing to medical research.
Participation is free; you are testing a drug that could benefit others in the future.
Cancer type and stage, medical history, overall health, past treatments, and other conditions. Some trials have age and gender restrictions.
Yes, you can leave a trial at any time for personal reasons, intolerable side effects, or if advised by your healthcare provider.
Informed consent will ensure full disclosure and confidentiality about the study, procedures, potential benefits, risks, and patient rights before signing up. Patients must adhere to the trial protocol.

